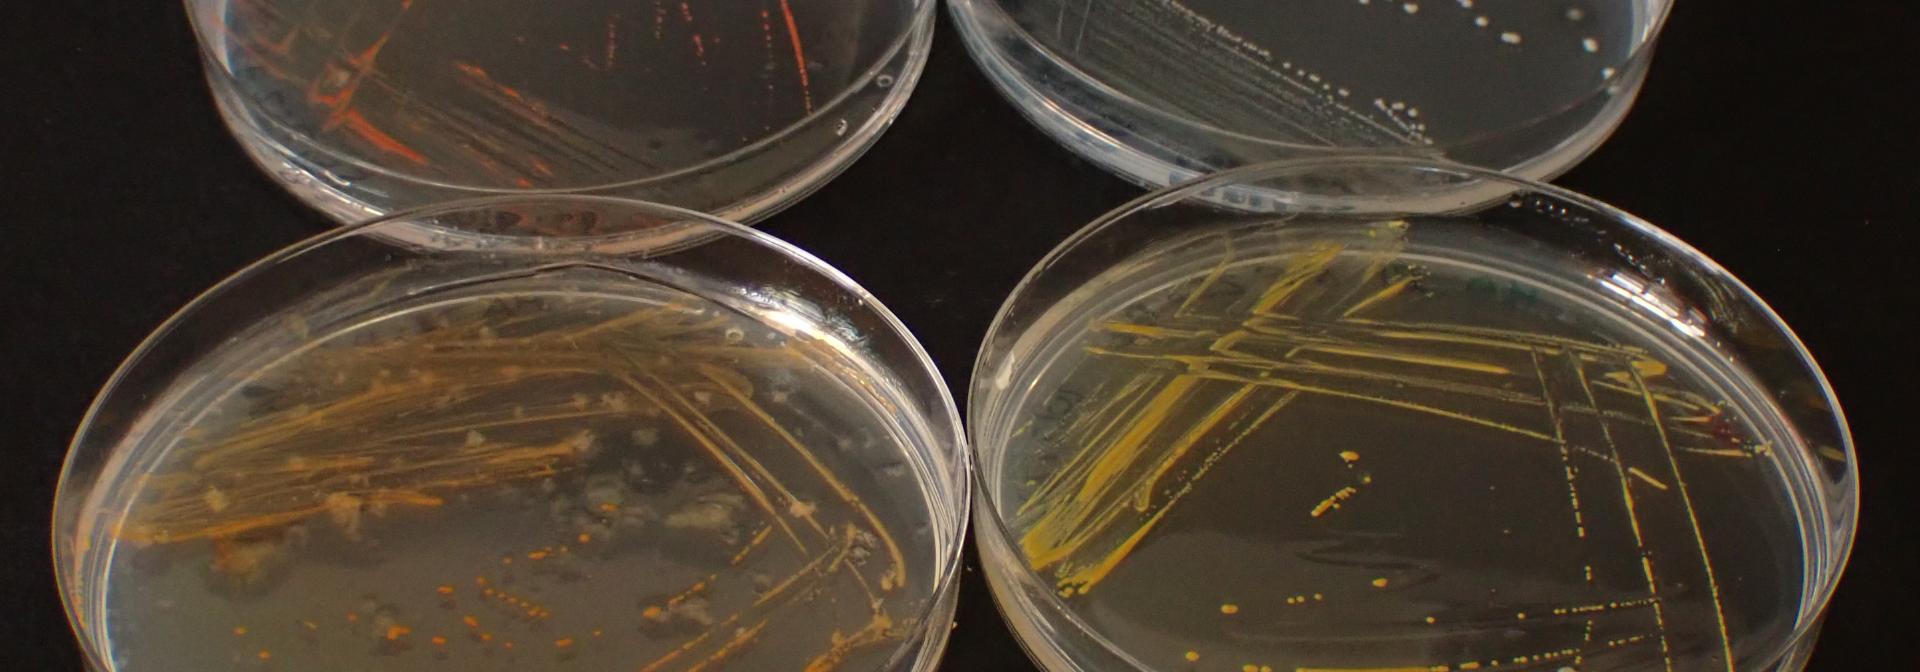
MMEB theme

MMEB

Marine Microbial Ecology and Biotechnology
 We investigate the application and ecology of marine microorganisms, especially those associated with corals, seagrasses and algae, and their host-microbe interactions using a wide array of approaches contributing to conservation, restoration and biotech.
We investigate the application and ecology of marine microorganisms, especially those associated with corals, seagrasses and algae, and their host-microbe interactions using a wide array of approaches contributing to conservation, restoration and biotech.
The group operates worldwide to characterise microbial communities and isolate microorganisms from a wide range of habitats and hosts to determine basically which microbes are where, when and why. We are especially interested in host-microbe interactions, which we assess through experimental and molecular approaches, but also by isolating microbes which then can be used to experimentally test hypotheses regarding for example their interactions among each other or with their host. We are investigating the microbiomes of marine species in production (aquaculture) and marine forest forming species like corals, seagrasses and large brown seaweeds, for example kelps, to test how microbes help the functioning of these systems and potential adaptation as well as how we can apply them in restorations actions.





